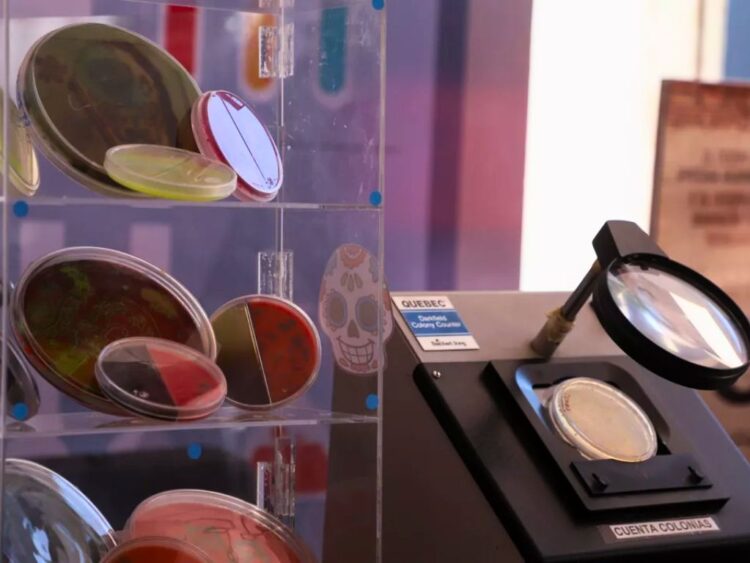
UAQ: seguridad alimentaria

En la UAQ, foro sobre seguridad alimentaria
Ciencia, inocuidad y colaboración interinstitucional
La Universidad Autónoma de Querétaro (UAQ) celebró el Segundo Foro de Inocuidad y Seguridad Alimentaria. Este Foro es un espacio académico para discutir los retos que enfrenta México en la producción segura de alimentos. Organizado por las facultades de Química e Informática, el encuentro reunió a más de 150 asistentes durante tres días. Las actividades incluyeron conferencias, talleres y una feria científica bajo el lema “Ciencia en tu plato”.
Formación, investigación y propuestas para la seguridad alimentaria
La doctora Montserrat Hernández Iturriaga, coordinadora del evento, explicó que el foro permitió compartir hallazgos de investigación, propuestas de mejora en la inocuidad de los alimentos y estrategias para fortalecer la formación de nuevos especialistas. Entre las ponencias destacó “Inocuidad en la producción y exportación de la carne”, impartida por la maestra Sara Abigail Oropeza González, de la Asociación Nacional de Establecimientos Tipo Inspección Federal (ANETIF), Además, La mesa “Desafíos de inocuidad de los alimentos en México”, que abordó riesgos sanitarios y regulatorios.
El foro forma parte de una estrategia institucional de la UAQ para vincular la investigación científica con los problemas reales que enfrenta la sociedad, especialmente en temas de salud pública, sostenibilidad y soberanía alimentaria.
Divulgación científica y compromiso social
Durante la inauguración, la rectora Silvia Amaya Llano subrayó la importancia del manejo correcto de los alimentos y de promover la ciencia para el bienestar colectivo.
“La divulgación científica ayuda a tomar decisiones informadas y a cuidar la salud, el medio ambiente y la seguridad alimentaria”, afirmó.
El foro también presentó la exposición “Mundo Microbiano de los Alimentos: lo bueno, lo malo y lo feo”. La exhibición mostró de forma didáctica cómo los microorganismos influyen en lo que comemos. Con estas actividades, la UAQ reafirma su compromiso con la cultura alimentaria responsable y el desarrollo sostenible del país.